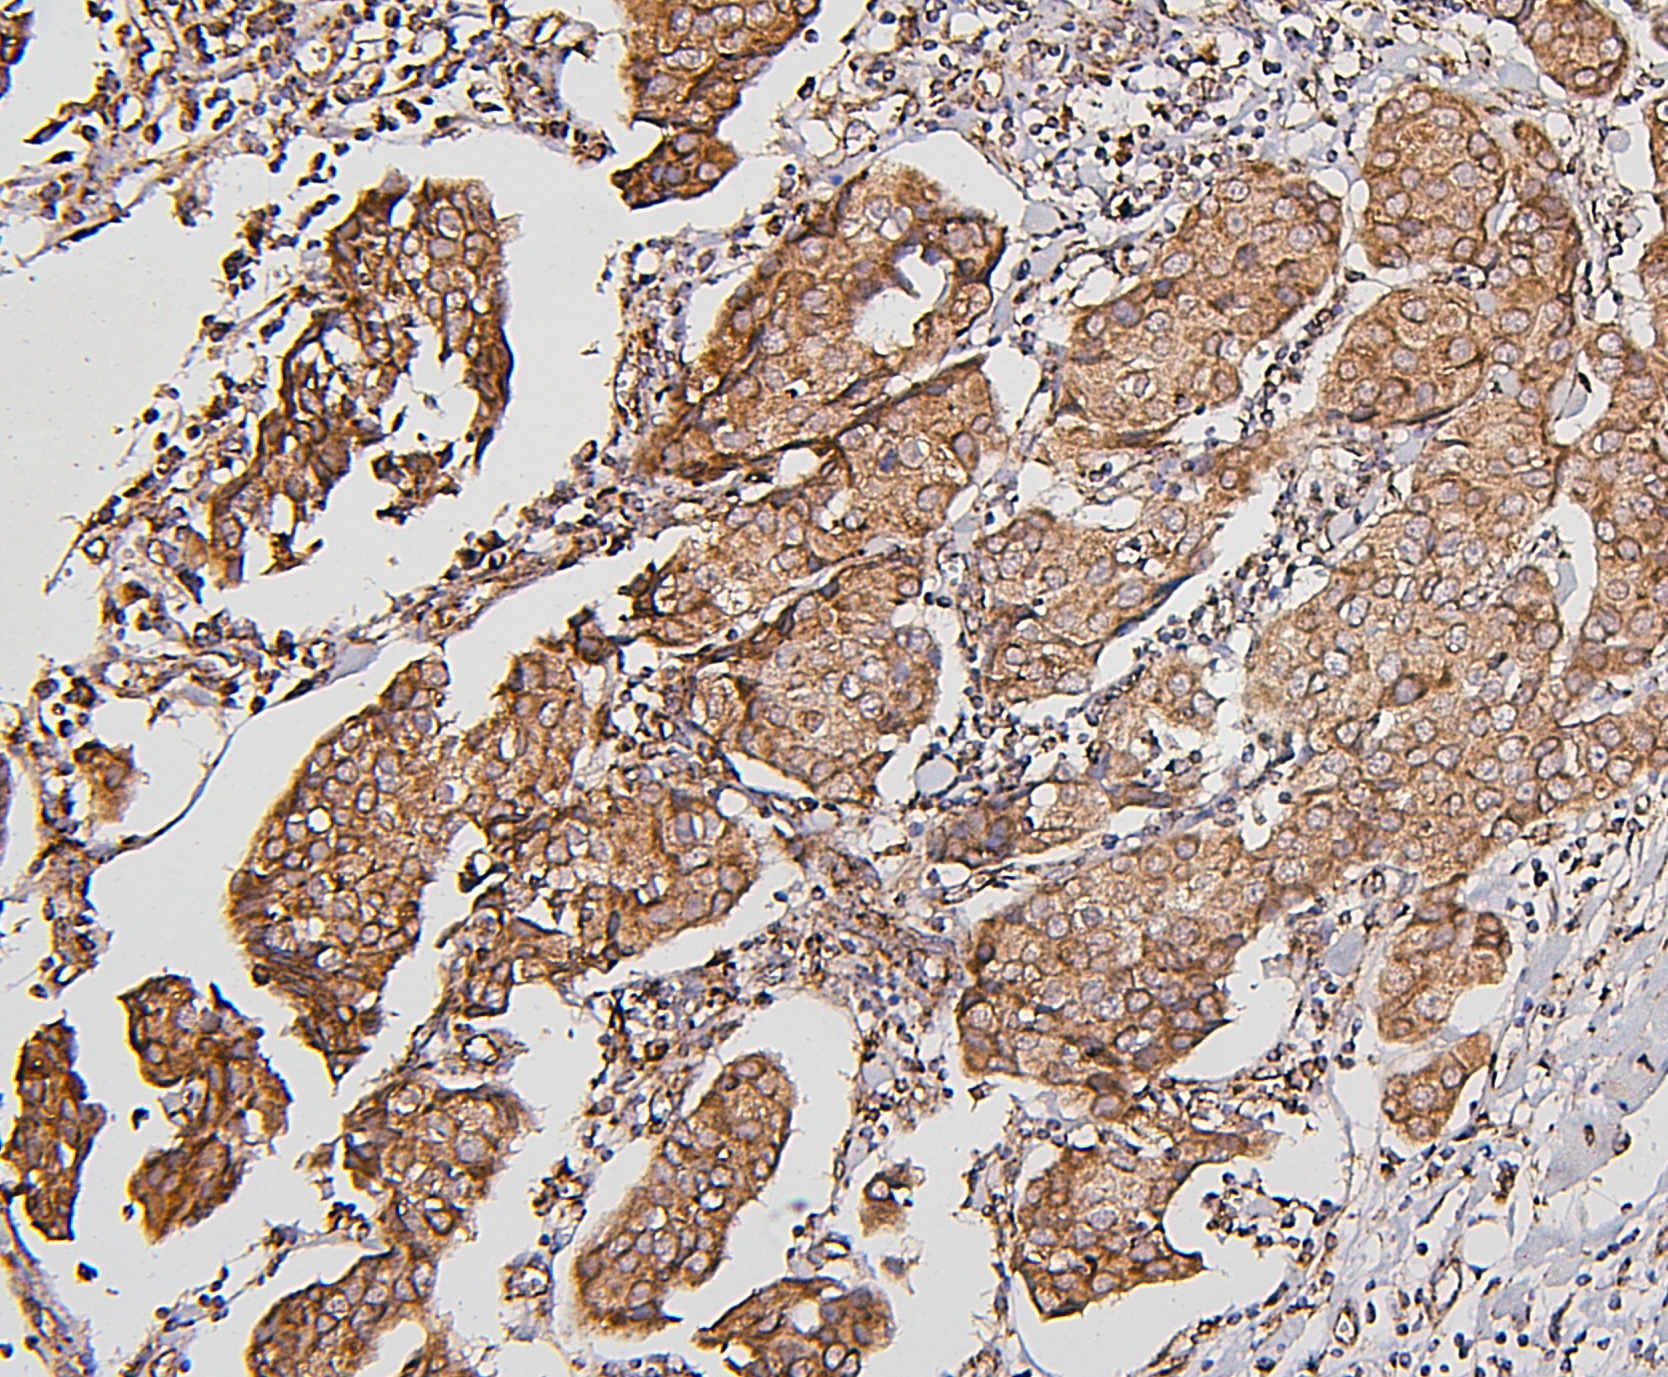
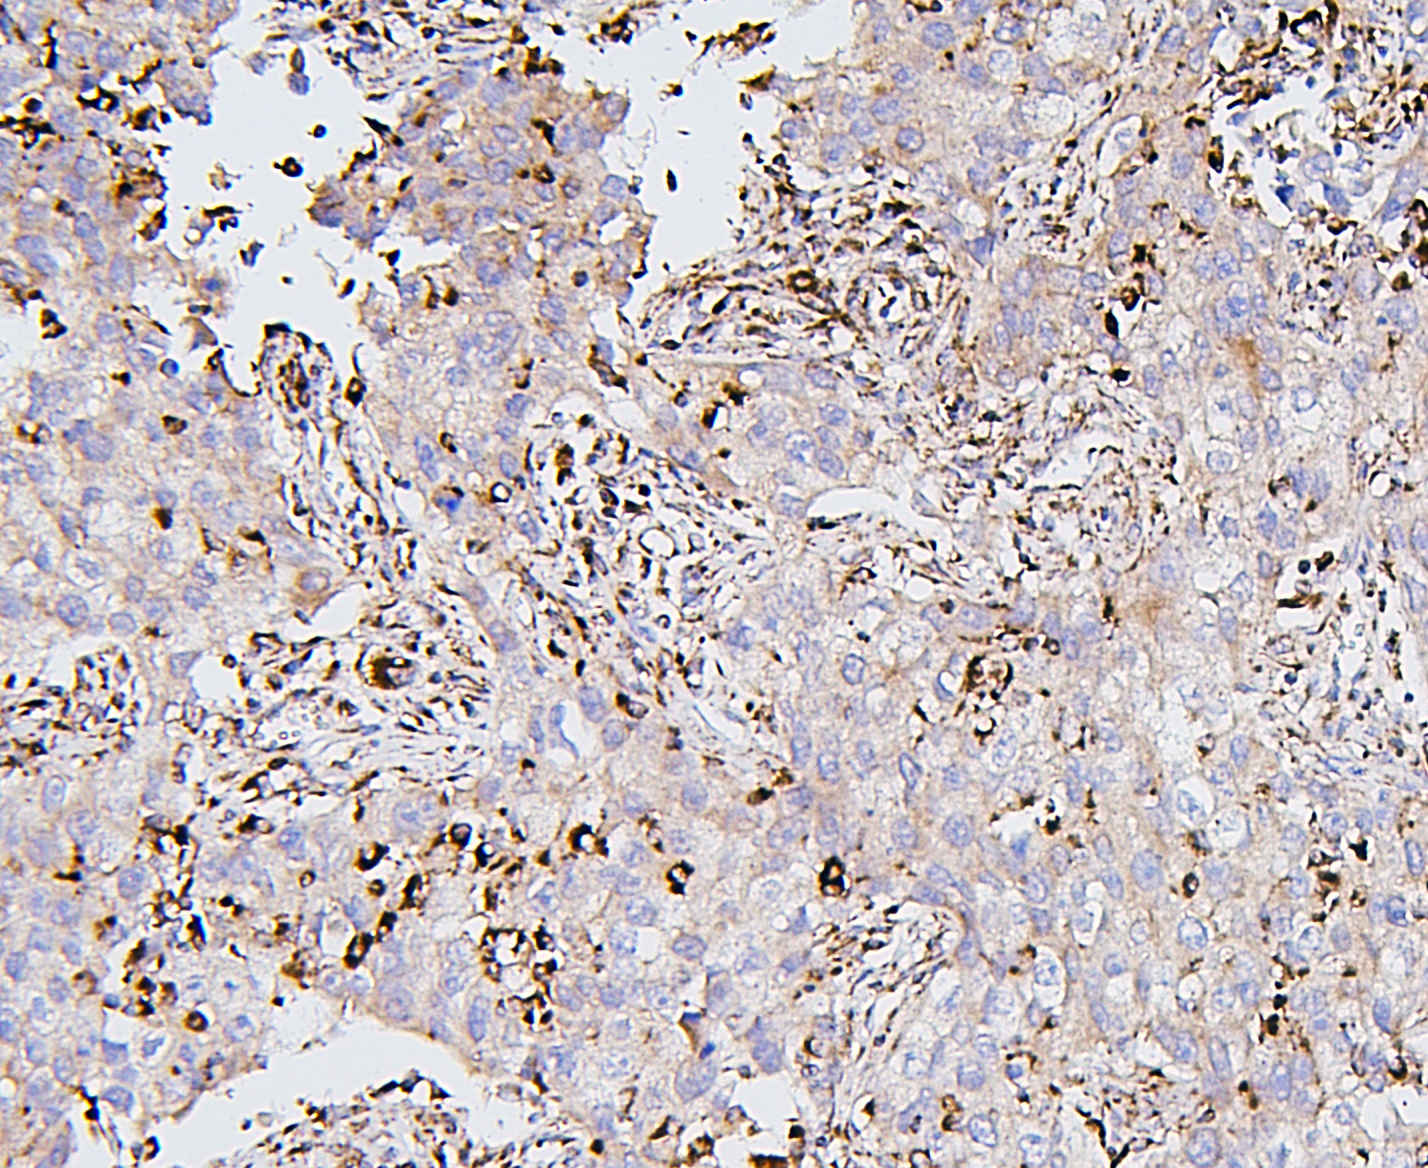

| Western blot (WB): | 1:500-2000 |
| Immunohistochemistry (IHC): | 1:50-400 |
| Immunocytochemistry/Immunofluorescence (ICC/IF): | 1:50-400 |
| Flow Cytometry (Fixed): | 1:50-200 |
| (Boiling the paraffin sections in 10mM citrate buffer,pH6.0,or PH8.0 EDTA repair liquid for 20 mins is required for the staining of formalin/paraffin sections.) Optimal working dilutions must be determined by end user. | |

Western blot analysis of anti-BAK/BAK1 antibody (M01163-1). The sample well of each lane was loaded with 30 ug of sample under reducing conditions.
Lane 1: human 293T whole cell lysates,
Lane 2: human A431 whole cell lysates,
Lane 3: human THP-1 whole cell lysates,
Lane 4: human MCF-7 whole cell lysates,
Lane 5: human PC-3 whole cell lysates.
After electrophoresis, proteins were transferred to a membrane. Then the membrane was incubated with mouse anti-BAK/BAK1 antigen affinity purified monoclonal antibody (M01163-1) at a dilution of 1:1000 and probed with a goat anti-mouse IgG-HRP secondary antibody (Catalog # BA1050). The signal is developed using ECL Plus Western Blotting Substrate (Catalog # AR1197). A specific band was detected for BAK/BAK1 at approximately 25 kDa. The expected band size for BAK/BAK1 is at 23 kDa.

IHC analysis of BAK/BAK1 using anti-BAK/BAK1 antibody (M01163-1).
BAK/BAK1 was detected in a paraffin-embedded section of human intestinal cancer tissue. Biotinylated goat anti-mouse IgG was used as secondary antibody. The tissue section was incubated with mouse anti-BAK/BAK1 Antibody (M01163-1) at a dilution of 1:200 and developed using Strepavidin-Biotin-Complex (SABC) (Catalog # SA1021) with DAB (Catalog # AR1027) as the chromogen.

IHC analysis of BAK/BAK1 using anti-BAK/BAK1 antibody (M01163-1).
BAK/BAK1 was detected in a paraffin-embedded section of human mammary cancer tissue. Biotinylated goat anti-mouse IgG was used as secondary antibody. The tissue section was incubated with mouse anti-BAK/BAK1 Antibody (M01163-1) at a dilution of 1:200 and developed using Strepavidin-Biotin-Complex (SABC) (Catalog # SA1021) with DAB (Catalog # AR1027) as the chromogen.

IHC analysis of BAK/BAK1 using anti-BAK/BAK1 antibody (M01163-1).
BAK/BAK1 was detected in a paraffin-embedded section of human tonsil tissue. Biotinylated goat anti-mouse IgG was used as secondary antibody. The tissue section was incubated with mouse anti-BAK/BAK1 Antibody (M01163-1) at a dilution of 1:200 and developed using Strepavidin-Biotin-Complex (SABC) (Catalog # SA1021) with DAB (Catalog # AR1027) as the chromogen.

IHC analysis of BAK/BAK1 using anti-BAK/BAK1 antibody (M01163-1).
BAK/BAK1 was detected in a paraffin-embedded section of human lung cancer tissue. Biotinylated goat anti-mouse IgG was used as secondary antibody. The tissue section was incubated with mouse anti-BAK/BAK1 Antibody (M01163-1) at a dilution of 1:200 and developed using Strepavidin-Biotin-Complex (SABC) (Catalog # SA1021) with DAB (Catalog # AR1027) as the chromogen.

IHC analysis of BAK/BAK1 using anti-BAK/BAK1 antibody (M01163-1).
BAK/BAK1 was detected in a paraffin-embedded section of mouse intestine tissue. Biotinylated goat anti-mouse IgG was used as secondary antibody. The tissue section was incubated with mouse anti-BAK/BAK1 Antibody (M01163-1) at a dilution of 1:200 and developed using Strepavidin-Biotin-Complex (SABC) (Catalog # SA1021) with DAB (Catalog # AR1027) as the chromogen.

IHC analysis of BAK/BAK1 using anti-BAK/BAK1 antibody (M01163-1).
BAK/BAK1 was detected in a paraffin-embedded section of rat intestine tissue. Biotinylated goat anti-mouse IgG was used as secondary antibody. The tissue section was incubated with mouse anti-BAK/BAK1 Antibody (M01163-1) at a dilution of 1:200 and developed using Strepavidin-Biotin-Complex (SABC) (Catalog # SA1021) with DAB (Catalog # AR1027) as the chromogen.

ICC/IF analysis of BAK1 using anti- BAK1 antibody (M01163-1)
BAK1 was detected in immunocytochemical section of A431 cell. Enzyme antigen retrieval was performed using IHC enzyme antigen retrieval reagent (AR0022) for 15 mins. The tissue section was blocked with 10% goat serum. The tissue section was then incubated with 2μg/mL mouse anti- BAK1 Antibody (M01163-1) overnight at 4°C. Fluoro488 Conjugated Goat Anti-mouse IgG (BA1126) was used as secondary antibody at 1:100 dilution and incubated for 30 minutes at 37°C. The section was counterstained with DAPI. Visualize using a fluorescence microscope and filter sets appropriate for the label used.

Flow Cytometry analysis of PC-3 cells using anti-BAK/BAK1 antibody (M01163-1).
Overlay histogram showing PC-3 cells stained with M01163-1 (Blue line). To facilitate intracellular staining, cells were fixed with 4% paraformaldehyde and permeabilized with permeabilization buffer. The cells were blocked with 10% normal goat serum. And then incubated with mouse anti-BAK/BAK1 Antibody (M01163-1) at 1:100 dilution for 30 min at 20°C. Fluoro488 conjugated goat anti-mouse IgG (BA1126) was used as secondary antibody at 1:100 dilution for 30 minutes at 20°C. Isotype control antibody (Green line) was mouse IgG at 1:100 dilution used under the same conditions. Unlabelled sample without incubation with primary antibody and secondary antibody (Red line) was used as a blank control.

Western blot analysis of anti-BAK/BAK1 antibody (M01163-1). The sample well of each lane was loaded with 30 ug of sample under reducing conditions.
Lane 1: human 293T whole cell lysates,
Lane 2: human A431 whole cell lysates,
Lane 3: human THP-1 whole cell lysates,
Lane 4: human MCF-7 whole cell lysates,
Lane 5: human PC-3 whole cell lysates.
After electrophoresis, proteins were transferred to a membrane. Then the membrane was incubated with mouse anti-BAK/BAK1 antigen affinity purified monoclonal antibody (M01163-1) at a dilution of 1:1000 and probed with a goat anti-mouse IgG-HRP secondary antibody (Catalog # BA1050). The signal is developed using ECL Plus Western Blotting Substrate (Catalog # AR1197). A specific band was detected for BAK/BAK1 at approximately 25 kDa. The expected band size for BAK/BAK1 is at 23 kDa.

IHC analysis of BAK/BAK1 using anti-BAK/BAK1 antibody (M01163-1).
BAK/BAK1 was detected in a paraffin-embedded section of human intestinal cancer tissue. Biotinylated goat anti-mouse IgG was used as secondary antibody. The tissue section was incubated with mouse anti-BAK/BAK1 Antibody (M01163-1) at a dilution of 1:200 and developed using Strepavidin-Biotin-Complex (SABC) (Catalog # SA1021) with DAB (Catalog # AR1027) as the chromogen.

IHC analysis of BAK/BAK1 using anti-BAK/BAK1 antibody (M01163-1).
BAK/BAK1 was detected in a paraffin-embedded section of human mammary cancer tissue. Biotinylated goat anti-mouse IgG was used as secondary antibody. The tissue section was incubated with mouse anti-BAK/BAK1 Antibody (M01163-1) at a dilution of 1:200 and developed using Strepavidin-Biotin-Complex (SABC) (Catalog # SA1021) with DAB (Catalog # AR1027) as the chromogen.

IHC analysis of BAK/BAK1 using anti-BAK/BAK1 antibody (M01163-1).
BAK/BAK1 was detected in a paraffin-embedded section of human tonsil tissue. Biotinylated goat anti-mouse IgG was used as secondary antibody. The tissue section was incubated with mouse anti-BAK/BAK1 Antibody (M01163-1) at a dilution of 1:200 and developed using Strepavidin-Biotin-Complex (SABC) (Catalog # SA1021) with DAB (Catalog # AR1027) as the chromogen.

IHC analysis of BAK/BAK1 using anti-BAK/BAK1 antibody (M01163-1).
BAK/BAK1 was detected in a paraffin-embedded section of human lung cancer tissue. Biotinylated goat anti-mouse IgG was used as secondary antibody. The tissue section was incubated with mouse anti-BAK/BAK1 Antibody (M01163-1) at a dilution of 1:200 and developed using Strepavidin-Biotin-Complex (SABC) (Catalog # SA1021) with DAB (Catalog # AR1027) as the chromogen.

IHC analysis of BAK/BAK1 using anti-BAK/BAK1 antibody (M01163-1).
BAK/BAK1 was detected in a paraffin-embedded section of mouse intestine tissue. Biotinylated goat anti-mouse IgG was used as secondary antibody. The tissue section was incubated with mouse anti-BAK/BAK1 Antibody (M01163-1) at a dilution of 1:200 and developed using Strepavidin-Biotin-Complex (SABC) (Catalog # SA1021) with DAB (Catalog # AR1027) as the chromogen.

IHC analysis of BAK/BAK1 using anti-BAK/BAK1 antibody (M01163-1).
BAK/BAK1 was detected in a paraffin-embedded section of rat intestine tissue. Biotinylated goat anti-mouse IgG was used as secondary antibody. The tissue section was incubated with mouse anti-BAK/BAK1 Antibody (M01163-1) at a dilution of 1:200 and developed using Strepavidin-Biotin-Complex (SABC) (Catalog # SA1021) with DAB (Catalog # AR1027) as the chromogen.

ICC/IF analysis of BAK1 using anti- BAK1 antibody (M01163-1)
BAK1 was detected in immunocytochemical section of A431 cell. Enzyme antigen retrieval was performed using IHC enzyme antigen retrieval reagent (AR0022) for 15 mins. The tissue section was blocked with 10% goat serum. The tissue section was then incubated with 2μg/mL mouse anti- BAK1 Antibody (M01163-1) overnight at 4°C. Fluoro488 Conjugated Goat Anti-mouse IgG (BA1126) was used as secondary antibody at 1:100 dilution and incubated for 30 minutes at 37°C. The section was counterstained with DAPI. Visualize using a fluorescence microscope and filter sets appropriate for the label used.

Flow Cytometry analysis of PC-3 cells using anti-BAK/BAK1 antibody (M01163-1).
Overlay histogram showing PC-3 cells stained with M01163-1 (Blue line). To facilitate intracellular staining, cells were fixed with 4% paraformaldehyde and permeabilized with permeabilization buffer. The cells were blocked with 10% normal goat serum. And then incubated with mouse anti-BAK/BAK1 Antibody (M01163-1) at 1:100 dilution for 30 min at 20°C. Fluoro488 conjugated goat anti-mouse IgG (BA1126) was used as secondary antibody at 1:100 dilution for 30 minutes at 20°C. Isotype control antibody (Green line) was mouse IgG at 1:100 dilution used under the same conditions. Unlabelled sample without incubation with primary antibody and secondary antibody (Red line) was used as a blank control.